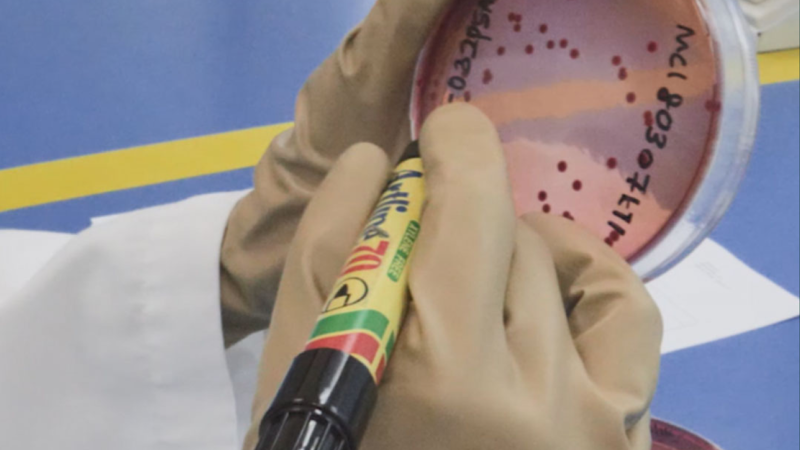

Erwiesener Vorteil
Reduzieren Sie Ihr Expositionsrisiko gegenüber Pathogenen. In einer Vergleichsstudie zeigte sich, dass die Fehlerwahrscheinlichkeit bei OP-Handschuhen anderer Marken um das 3,5-fache höher ist als bei Biogel Handschuhen.
Qualitätsprüfungen der Biogel Handschuhe
-
Biogel® OP-Handschuhe durchlaufen vor dem Verlassen unseres Werkes eine Reihe von Qualitätsprüfungen - alle Tests sind zum Schutz Ihrer Sicherheit entwickelt worden. Dies wird durch unseren branchenführenden AQL-Wert (Acceptance Quality Level - annehmbare Qualitätsgrenzlage) von nur 0,42 und einer klinischen Vergleichsstudie belegt, die zu dem Schluss kommt, dass die Fehlerwahrscheinlichkeit bei OP-Handschuhen anderer Marken um das 3,5-fache höher ist als bei Biogel Handschuhen.3
-

Prüfung der physikalischen Eigenschaften
Biogel Handschuhe übertreffen die Anforderungen der Normen für Reißkraft, Zugestigkeit Dehnung.4
-
Mikrobiologische Prüfung
Alle unsere Handschuhe werden strengen mikrobiologischen Prüfungen unterworfen und mehrere Male gewaschen, um verbliebene Proteine, Chemikalien und Endotoxine auf die geringstmöglichen Konzentrationen zu bringen.
-

Prüfung durch Druckluftbefüllung
100 % der Biogel Handschuhe werden mit Druckluft befüllt, um sie auf Löcher zu prüfen.
-

Prüfung bei jedem Schritt
Wir prüfen außerdem jede Komponente im Herstellungsverfahren, einschließlich Umgebung, Rohmaterialien und Verpackung. Hohe Qualität bedeutet weniger Handschuhfehler und gewährleistet den Schutz und die Wertigkeit, die Sie benötigen.
Gehören Sie zur Risikogruppe?
Bei 1 von 10 Eingriffen ist das OP-Personal dem Patientenblut ausgesetzt.
Finde Sie heraus, warum.Referenzen
- Mölnlycke Health Care. In use surgical glove failure rate comparison. Report no: G009-005. 2009. Data on file.
- Naver, Lars P.S.; Gottrup, Finn; Incidence of glove perforations in gastrointestinal surgery and the protective effect of double gloves: A prospective, Randomized controlled study; Eur J. Surg 2000; Vol 166 pp. 293-295.
- Aldlyami, Ehab; Kulkarni, Ashwin; et al. Latex-free gloves Safer for Whom?; The Journal of Arthroplasty; 2010; Vol. 25 No. 1 pp. 27-30.
- MKT004. Why Choose Biogel. 2009. Data on file.
- Nicolai P, Aldam CH, Allen PW. Increased awareness of glove perforation in major joint replacement. A prospective, randomised study of Regent Biogel Reveal gloves. J Bone Joint Surg Br. 1997 May;79(B):371-3.
- Collins J. A Clinical Evaluation of Polyisoprene Biogel Orthopaedic Surgical Gloves. Design Validation DP36_/3.6.1, Mölnlycke Health Care 2011.
- Collins J. An Open label Evaluation of the Biogel PI ProFit Surgical Glove. CIR_BioGel_PI_ProFit_Design Validation DP35_/3.6.1, Mölnlycke Health Care. 2012.
- Collins J. A Clinical Investigation to Evaluate the Biogel PI Micro Surgical Glove to Ensure Performance as Intended. Clinical Investigation Report, Mölnlycke Health Care 2014.